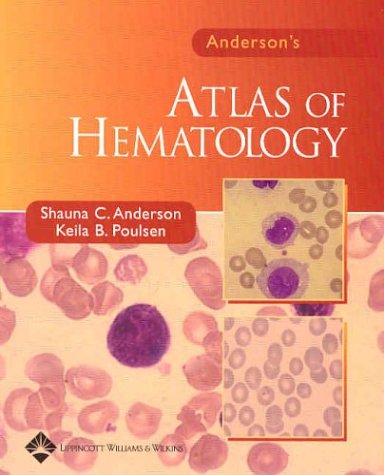
Book Image

production
/viewbook/list/all/?page=747
/
/static/
None

Anderson, Bartlett & East's Texas Uniform Commercial Code...
Roger Bartlett
Thomson West
Not available
0314922806
This publication contains the full text and annotations of the Texas Uniform Commercial Code, official comments to the Uniform Commercial Code, and... comments prepared by the Business Law Committee of the State Bar of Texas. It also contains related state and federal statutes, including Business and Commerce Code Chapter 17 and chapters relating to deceptive trade practices, assignments for the benefit of creditors, the Uniform Fraudulent Transfer Act, and statute of frauds. Also included are chapters relating to the Uniform Electronic Transactions Act, the United States Code Annotated, the Magnuson-Moss Warranty Act, and electronic signatures.

Anderson/Intro.To Flight-Chaps 5-8 Custom F/U Of I
Not Available
Not available
Not available
Not available

ANDERSON ON ADVOCACY
Not Available
Not available
Not available
Not available
Anderson's Atlas of Hematology
Shauna C. Anderson
Lippincott Williams & Wilkins
Not available
078172662X
This essential primer is a print companion to Anderson's Electronic Atlas of Hematology and Anderson's Electronic Atlas of Hematologic Disorders. With... four-color illustrations, this manual describes and identifies the maturation sequence of developing blood cells, as well as categorizing cell abnormalities. Coverage includes both normal and abnormal cells, and the format allows for benchtop reference. Written by a well-known educator in the field, this text follows the CLS Body of Knowledge curriculum for MTs and MLTs.

Andersons Blaw & Legal Environment (Custom) (Text)
Not Available
Not available
Not available
Not available

Anderson's Business Law and the Legal Environment Comprehensive...
Twomey
Cenage
Not available
1111663572

Anderson's Business Law and the Legal Environment, Comprehensive...
Not Available
Cenage Learning
Not available
1111720533

Anderson's Business Law and the Legal Environment, Comprehensive...
David P. Twomey
South-Western College/West
Not available
0324786662
In addition to preparing you to ace your business law course, ANDERSON'S BUSINESS LAW AND THE LEGAL ENVIRONMENT, COMPREHENSIVE VOLUME, 21st Edition,... provides information and resources to assist you in studying for the CPA exam. This #1 summarized case business law text on the market today helps you grasp key legal concepts and principles by reinforcing your understanding through applications and examples of real-world dilemmas, issues, and problems. Current, comprehensive, easy-to-understand and fascinating to read, ANDERSON'S BUSINESS LAW will help you prepare you for class and give you all the resources you need to succeed in your business law course.

Anderson's Business Law and the Legal Environment, Comprehensive...
David P. Twomey
South-Western College/West
Not available
0324638183
Not only helping you to ace your business law course, ANDERSON'S BUSINESS LAW AND THE LEGAL ENVIRONMENT, COMPREHENSIVE VOLUME, 20th Edition, also... provides the information and resources to assist you in studying for the CPA exam. The #1 business law text with summarized cases on the market today, this top-selling book helps you grasp key legal concepts and principles, reinforcing your understanding with applications and examples of real-world dilemmas, issues, and problems. Current, comprehensive, easy-to-understand and fascinating to read, ANDERSON'S BUSINESS LAW will help you prepare you for every class lecture and give you all the resources you need to do your best on exams.

Anderson's Business Law and the Legal Environment, Standard Volume
David P. Twomey
South-Western College/West
Not available
0324786689
In addition to preparing you to ace your business law course, ANDERSON'S BUSINESS LAW AND THE LEGAL ENVIRONMENT, STANDARD VOLUME, 21st Edition, provides... information and resources to assist you in studying for the CPA exam. A briefer version of the #1 summarized case business law text on the market today, this book helps you grasp key legal concepts and principles by reinforcing your understanding through applications and examples of real-world dilemmas, issues, and problems. Current, comprehensive, easy-to-understand and fascinating to read, ANDERSON'S BUSINESS LAW AND THE LEGAL ENVIRONMENT will help you prepare you for class and give you all the resources you need to succeed in your business law course.

ANDERSON'S BUSINESS LAW UALBANY CUSTOM
Not Available
Not available
Not available
Not available

ANDERSON'S BUSINESS LAW W/SARBANNE OXLE
Not Available
Not available
Not available
Not available

ANDERSON'S OHIO CONSUMER LAW MANUAL
Not Available
Not available
Not available
Not available

Anderson's Ohio Criminal and Traffic Field Guide
Publisher's Editorial Staff
LEXISNEXIS
Not available
0769853714
LexisNexis Law Enforcement Publications is pleased to present the newest edition of Anderson's Ohio Criminal and Traffic Law Field Guide. We have... conveniently combined the Criminal Code and Traffic Code books into one! Anderson's Ohio Field Guide is a durable, pocket-sized guide that clearly and concisely presents the elements of key statutes of the criminal law and motor vehicle offenses. The Field Guide also includes a Penalty Table inside the front cover and convenient edge-of-page tabs for quick reference, making this Guide a true field reference. Its ease-of-use is enhanced by the side-spiral binding, allowing the Field Guide to lay open flat on your desk or dash board. The Anderson's Ohio Criminal and Traffic Law Field Guide's comprehensive coverage, durability, and pocket size make it the perfect reference to carry in your gear bag, to leave in your car, or to have handy for briefings or training.

Anderson's Ohio Criminal Law Handbook with CD-ROM
Publisher's Editorial Staff
LEXISNEXIS
Not available
0769854265
Anderson's Ohio Criminal Law Handbook contains Title 29, the Ohio Criminal Code, as well as: • Miscellaneous related statutes • United States... Constitution and Ohio Constitution (selected provisions) • Table of Penalties and Index of Offenses • Elements of Offenses • Time Table in Criminal Cases • Ohio Rules of Procedure (Criminal / Evidence / Juvenile / Traffic) • Application for Crime Victim Compensation • Selected Rules of Superintendent for the Courts of Ohio • Comprehensive General Index Anderson's Ohio Criminal Law Handbook features a bound-in CD-ROM that includes all the content from the print version plus additional annotations and research references too voluminous to include in the book. The CD-ROM version offers robust searching capabilities and the option to copy-and-paste material into your word processing or email documents.
 '
'





